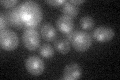
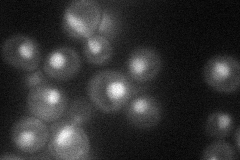
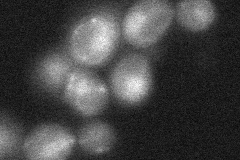

View description
Subunit of the NuA3 histone acetyltransferase complex that acetylates histone H3; contains PHD finger domain that interacts with methylated histone H3
Localization:
Intensity:
Fold change:
Significance:
-
C’ GFP library in SD
nucleus19.47 -
N' NOP1pr-GFP in SD
nucleus32.2429 -
N' TEF2pr-mCherry in SD

nucleus17.0023 -
N' NATIVEpr-GFP in SD

nucleus22.3148 -
N' TEF2pr-VC and Cyto-VN in SD
nucleus28.4283 -
C’ GFP library in SD+DTT

nucleus20.091.03No -
C’ GFP library in SD+H2O2

nucleus23.481.2No -
C’ GFP library in Starvation Media

nucleus18.340.94No -
C’ GFP library on the background of Pup2-DaMP

N/A -
C’ GFP library on the background of CCT mutant

N/A0N/AYes
